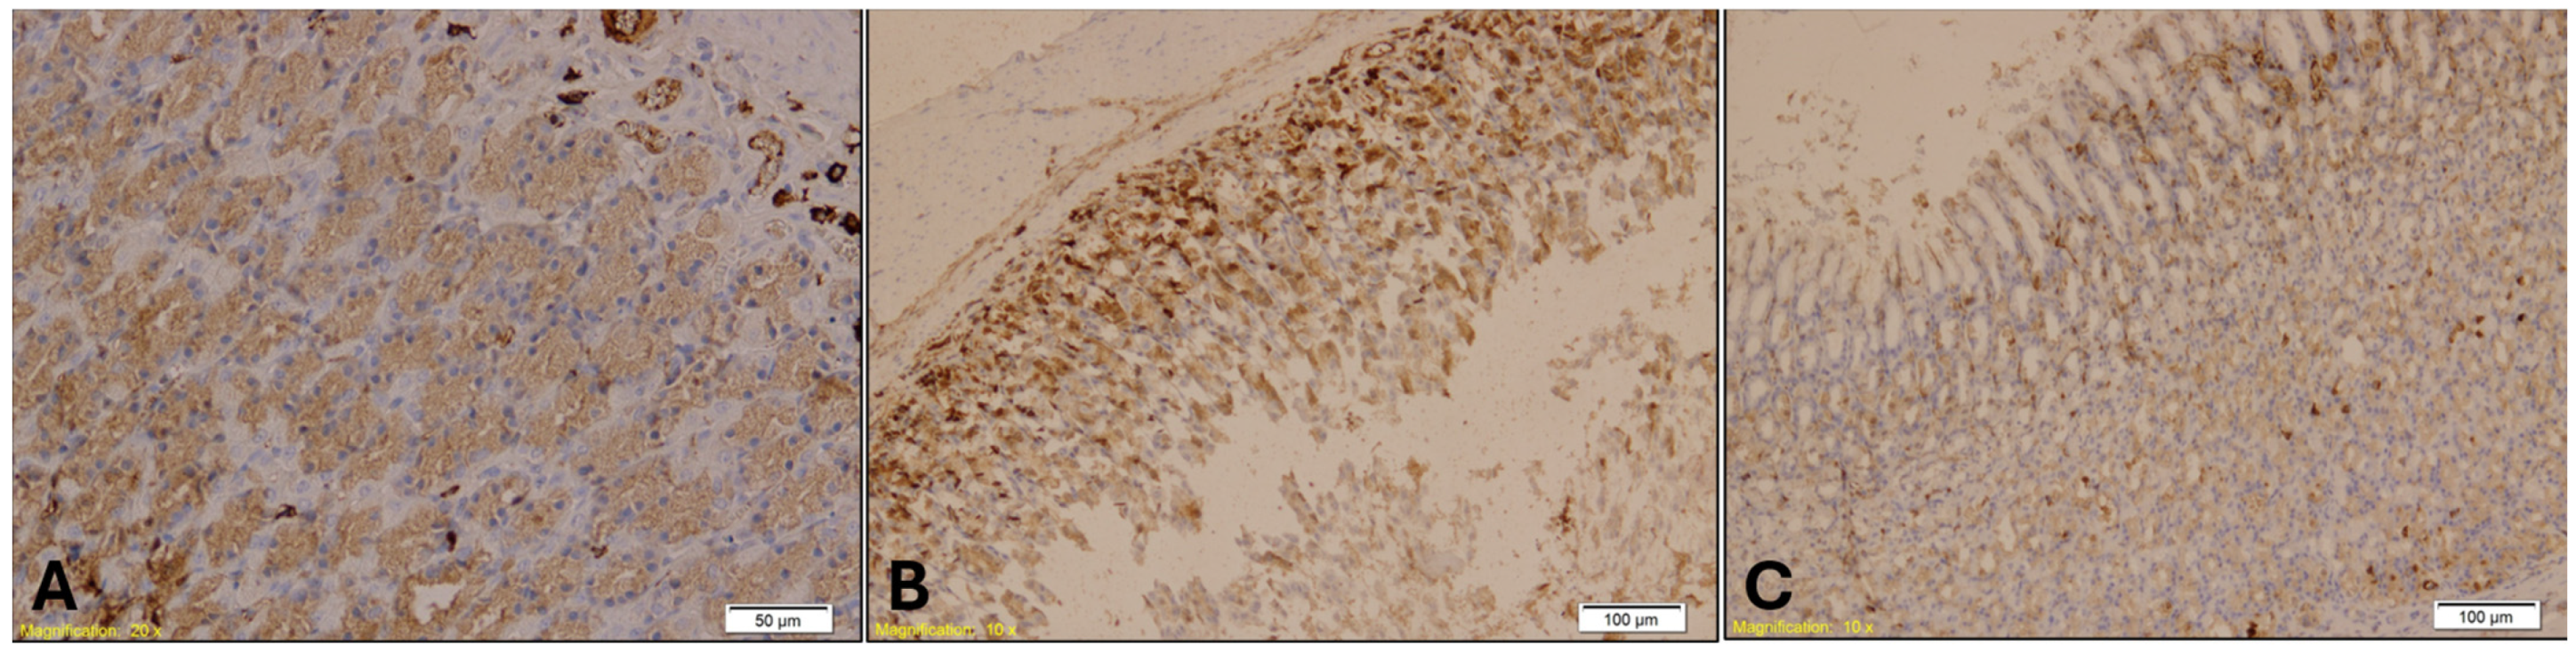
Ijms 26 07578 g011

Histological and Immunohistochemical Evidence in Hypothermia-Related Death: An Experimental Study
Abstract
1. Introduction
2. Results
2.1. Histological Findings
2.2. Immunohistochemical Findings
3. Discussion
4. Materials and Methods
4.1. Experimental Design
- Control Group (K) (n = 7): Exposed to hypothermic conditions without any drug treatment, serving as a model for primary hypothermia.
- Benzodiazepine Group (B) (n = 7): Administered diazepam (5 mg/kg body weight) daily in the morning for two weeks prior to hypothermic exposure, modeling secondary hypothermia induced by benzodiazepine use.
- Alcohol Group (A) (n = 7): Administered red wine (Vranac, 14.0% alcohol, 10 mL/kg body weight) once daily in the morning for two weeks before hypothermic exposure, simulating secondary hypothermia caused by alcohol intake.
4.2. Animal Welfare and Ethical Approval
4.3. Hypothermia Induction and Monitoring
4.4. Histological Investigation
4.5. Immunohistochemical Investigation
- E-cadherin (mouse monoclonal, 1:200)—Kidney: E-cadherin is a transmembrane protein involved in epithelial cell adhesion and polarity. Its expression is typically preserved in distal renal tubules but reduced in proximal segments. Loss or reduction in E-cadherin staining may reflect epithelial stress or ischemic injury, making it a useful marker for assessing hypothermia-induced renal damage.
- Myeloperoxidase (MPO) (rabbit monoclonal, 1:100)—Lung and Spleen: MPO is a non-specific marker of neutrophilic infiltration and oxidative stress. It is used to evaluate inflammatory responses and immune activation, which may be altered in hypothermia and further modulated by alcohol or benzodiazepine exposure.
- Cytokeratin 7 (CK7) (rabbit monoclonal, 1:100)—Gastroesophageal Junction: CK7 is an intermediate filament protein expressed in epithelial cells, particularly in glandular and transitional zones. Its expression helps assess epithelial integrity and stress responses in hypothermia-related gastrointestinal injury.
- Cytokeratin 20 (CK20) (mouse monoclonal, 1:150)—Gastroesophageal Junction: CK20 complements CK7 in characterizing epithelial differentiation and stress. Its expression pattern can help distinguish hypothermia-induced epithelial changes from other causes of mucosal injury.
- o
- (−): No staining.
- o
- (+): Weak staining.
- o
- (++): Moderate staining.
- o
- (+++): Strong staining.
- o
- (++++): Very strong staining.
4.6. Statistical Analysis
5. Conclusions
Author Contributions
Funding
Institutional Review Board Statement
Informed Consent Statement
Data Availability Statement
Conflicts of Interest
Abbreviations
| ADH | Alcohol Dehydrogenase |
| ALDH | Aldehyde Dehydrogenase |
| CK7 | Cytokeratin 7 |
| CK20 | Cytokeratin 20 |
| E-cadherin | Epithelial cadherin |
| G-CSF | Granulocyte-Colony Stimulating Factor |
| HIF-1α | Hypoxia-Inducible Factor 1 alpha |
| IL-6 | Interleukin 6 |
| MPO | Myeloperoxidase |
| NF-κB | Nuclear Factor kappa B |
| ROS | Reactive Oxygen Species |
| TNF-α | Tumor Necrosis Factor alpha |
References
- Soar, J.; Perkins, G.D.; Abbas, G.; Alfonzo, A.; Barelli, A.; Bierens, J.J.L.M.; Brugger, H.; Deakin, C.D.; Dunning, J.; Georgiou, M.; et al. European Resuscitation Council Guidelines for Resuscitation 2010 Section 8. Cardiac Arrest in Special Circumstances: Electrolyte Abnormalities, Poisoning, Drowning, Accidental Hypothermia, Hyperthermia, Asthma, Anaphylaxis, Cardiac Surgery, Trauma, Pregnancy, Electrocution. Resuscitation 2010, 81, 1400–1433. [Google Scholar] [CrossRef]
- Nixdorf-Miller, A.; Hunsaker, D.M.; Hunsaker, J.C. Hypothermia and Hyperthermia Medicolegal Investigation of Morbidity and Mortality from Exposure to Environmental Temperature Extremes. Arch. Pathol. Lab. Med. 2006, 130, 1297–1304. [Google Scholar] [CrossRef]
- Lim, C.; Duflou, J. Hypothermia Fatalities in a Temperate Climate: Sydney, Australia. Pathology 2008, 40, 46–51. [Google Scholar] [CrossRef]
- Teresiński, G.; Buszewicz, G.; Ma̧dro, R. Biochemical Background of Ethanol-Induced Cold Susceptibility. Leg. Med. 2005, 7, 15–23. [Google Scholar] [CrossRef]
- Zachariah, S.B.; Zachariah, A.; Ananda, R.; Stewart, J.T. Hypothermia and Thermoregulatory Derangements Induced by Valproic Acid. Neurology 2000, 55, 150–151. [Google Scholar] [CrossRef]
- Kreuzer, P.; Landgrebe, M.; Wittmann, M.; Schecklmann, M.; Poeppl, T.B.; Hajak, G.; Langguth, B. Hypothermia Associated with Antipsychotic Drug Use: A Clinical Case Series and Review of Current Literature. J. Clin. Pharmacol. 2012, 52, 1090–1097. [Google Scholar] [CrossRef]
- Gordon, C.J. Response of the Thermoregulatory System to Toxic Insults. Front. Biosci.-Elite 2010, 2, 293–311. [Google Scholar] [CrossRef]
- Michaud, K.; Romain, N.; Giroud, C.; Brandt, C.; Mangin, P. Hypothermia and Undressing Associated with Non-Fatal Bromazepam Intoxication. Forensic. Sci. Int. 2001, 124, 112–114. [Google Scholar] [CrossRef]
- Zonnenberg, C.; Bueno-de-Mesquita, J.M.; Ramlal, D.; Blom, J.D. Hypothermia Due to Antipsychotic Medication: A Systematic Review. Front. Psychiatry 2017, 8, 165. [Google Scholar] [CrossRef]
- Dolinak, D.; Matshes, E.; Lew, E.O. Forensic Pathology: Principles and Practice; Academic Press: Cambridge, MA, USA, 2005; ISBN 9780122199516. [Google Scholar]
- Madea, B.; Tsokos, M.; Preuß, J. Death Due to Hypothermia Morphological Findings, Their Pathogenesis and Diagnostic Value. In Forensic Pathology Reviews; Humana Press: Totowa, NJ, USA, 2009. [Google Scholar]
- Turk, E.E. Hypothermia. Forensic Sci. Med. Pathol. 2010, 6, 106–115. [Google Scholar] [CrossRef]
- Payne-James, J.; Byard, R.W. Hypothermia. In Forensic and Legal Medicine: Clinical and Pathological Aspects; CRC Press: Boca Raton, FL, USA, 2024. [Google Scholar]
- Chudakov, A.Y.; Tolmachev, I.A.; Kuznetsova, A.A. Uncharacteristic Soft Tissue Injuries Detectable in Cases of Death from General Accidental Hypothermia. Forensic Med. Expert. 2025, 68, 20. [Google Scholar] [CrossRef] [PubMed]
- Simmonds, M.; Llewellyn, A.; Walker, R.; Fulbright, H.; Walton, M.; Hodgson, R.; Bojke, L.; Stewart, L.; Dias, S.; Rush, T.; et al. Anti-VEGF Drugs Compared with Laser Photocoagulation for the Treatment of Proliferative Diabetic Retinopathy: A Systematic Review and Individual Participant Data Meta-Analysis. Health Technol. Assess. 2025, 1, 1–75. [Google Scholar] [CrossRef] [PubMed]
- Dettmeyer, R.B. The Role of Histopathology in Forensic Practice: An Overview. Forensic Sci. Med. Pathol. 2014, 10, 401–412. [Google Scholar] [CrossRef]
- You, J.S.; Kim, J.Y.; Yenari, M.A. Therapeutic Hypothermia for Stroke: Unique Challenges at the Bedside. Front. Neurol. 2022, 13, 951586. [Google Scholar] [CrossRef]
- Mack, T.; Parai, J.L.; Milroy, C.M. Establishing Vitreous Glucose and Beta-Hydroxybutyrate Thresholds to Assist in the Diagnosis of Hypothermia. Forensic Sci. Int. 2024, 356, 111963. [Google Scholar] [CrossRef]
- Hejna, P.; Zátopková, L.; Tsokos, M. The Diagnostic Value of Synovial Membrane Hemorrhage and Bloody Discoloration of Synovial Fluid (“inner Knee Sign”) in Autopsy Cases of Fatal Hypothermia. Int. J. Leg. Med. 2012, 126, 415–419. [Google Scholar] [CrossRef]
- Fineschi, V.; Neri, M.; Di Donato, S.; Pomara, C.; Riezzo, I.; Turillazzi, E. An Immunohistochemical Study in a Fatality Due to Ovarian Hyperstimulation Syndrome. Int. J. Leg. Med. 2006, 120, 293–299. [Google Scholar] [CrossRef]
- Pennisi, G.; Torrisi, M.; Cocimano, G.; Esposito, M.; Salerno, M.; Sessa, F. Vitality Markers in Forensic Investigations: A Literature Review. Forensic Sci. Med. Pathol. 2022, 19, 103–116. [Google Scholar] [CrossRef]
- Salerno, M.; Cocimano, G.; Roccuzzo, S.; Russo, I.; Piombino-Mascali, D.; Márquez-Grant, N.; Zammit, C.; Esposito, M.; Sessa, F. New Trends in Immunohistochemical Methods to Estimate the Time since Death: A Review. Diagnostics 2022, 12, 2114. [Google Scholar] [CrossRef]
- Preuß, J.; Lignitz, E.; Dettmeyer, R.; Madea, B. Pancreatic Changes in Cases of Death Due to Hypothermia. Forensic Sci. Int. 2007, 166, 194–198. [Google Scholar] [CrossRef]
- Preuß, J.; Dettmeyer, R.; Lignitz, E.; Madea, B. Fatty Degeneration in Renal Tubule Epithelium in Accidental Hypothermia Victims. Forensic Sci. Int. 2004, 141, 131–135. [Google Scholar] [CrossRef] [PubMed]
- Palmiere, C.; Mangin, P. Postmortem Biochemical Investigations in Hypothermia Fatalities. Int. J. Leg. Med. 2013, 127, 267–276. [Google Scholar] [CrossRef] [PubMed]
- Preuss, J.; Dettmeyer, R.; Lignitz, E.; Madea, B. Fatty Degeneration of Myocardial Cells as a Sign of Death Due to Hypothermia versus Degenerative Deposition of Lipofuscin. Forensic Sci. Int. 2006, 159, 1–5. [Google Scholar] [CrossRef] [PubMed]
- Ishikawa, T.; Miyaishi, S.; Tachibana, T.; Ishizu, H.; Zhu, B.L.; Maeda, H. Fatal Hypothermia Related Vacuolation of Hormone-Producing Cells in the Anterior Pituitary. Leg. Med. 2004, 6, 157–163. [Google Scholar] [CrossRef]
- Doberentz, E.; Madea, B. Microscopic Examination of Pituitary Glands in Cases of Fatal Accidental Hypothermia. Forensic Sci. Res. 2017, 2, 132–138. [Google Scholar] [CrossRef]
- Yamada, S.; Shimomura, Y.; Ohsaki, M.; Fujisaki, A.; Tsuruya, K.; Iida, M. Hypothermia-Induced Acute Kidney Injury in a Diabetic Patient with Nephropathy and Neuropathy. Intern. Med. 2010, 49, 171–174. [Google Scholar] [CrossRef][Green Version]
- Yoon, H.J.; Kim, M.C.; Park, J.W.; Yang, M.A.; Lee, C.B.; Sun, I.O.; Lee, K.Y. Hypothermia-Induced Acute Kidney Injury in an Elderly Patient. Korean J. Intern. Med. 2014, 29, 111. [Google Scholar] [CrossRef]
- Vahdatpour, C.; Sussman, A.; Mahr, T. A Case Report of Severe Hypothermia Complicated by Acute Respiratory Distress Syndrome. Respir. Med. Case Rep. 2019, 28, 100869. [Google Scholar] [CrossRef]
- Mehta, A.J.; Guidot, D.M. Alcohol and the Lung. Alcohol Res. 2017, 38, 243. [Google Scholar] [CrossRef]
- Hleșcu, A.A.; Grigoraș, A.; Ianole, V.; Amalinei, C. Advanced Diagnostic Tools in Hypothermia-Related Fatalities—A Pathological Perspective. Diagnostics 2024, 14, 739. [Google Scholar] [CrossRef]
- Elmsjö, A.; Ward, L.J.; Horioka, K.; Watanabe, S.; Kugelberg, F.C.; Druid, H.; Green, H. Biomarker Patterns and Mechanistic Insights into Hypothermia from a Postmortem Metabolomics Investigation. Sci. Rep. 2024, 14, 18972. [Google Scholar] [CrossRef]
- Zhao, R.Z.; Jiang, S.; Zhang, L.; Yu, Z. Bin Mitochondrial Electron Transport Chain, ROS Generation and Uncoupling (Review). Int. J. Mol. Med. 2019, 44, 3–15. [Google Scholar]
- Juan, C.A.; de la Lastra, J.M.P.; Plou, F.J.; Pérez-Lebeña, E. The Chemistry of Reactive Oxygen Species (Ros) Revisited: Outlining Their Role in Biological Macromolecules (DNA, Lipids and Proteins) and Induced Pathologies. Int. J. Mol. Sci. 2021, 22, 4642. [Google Scholar] [CrossRef]
- Song, S.-J.; Wu, G.-C.; Yi, L.; Liu, X.; Jiang, M.-M.; Zhang, X.-C.; Yin, Z.-F.; Gu, W.; Ruan, Y. Heat Shock Proteins in Hypothermia: A Review. Front. Mol. Biosci. 2025, 12, 1564364. [Google Scholar] [CrossRef]
- Hussar, P. Apoptosis Regulators Bcl-2 and Caspase-3. Encyclopedia 2022, 2, 1624–1636. [Google Scholar] [CrossRef]
- Ageeva, T.; Rizvanov, A.; Mukhamedshina, Y. NF-ΚB and JAK/STAT Signaling Pathways as Crucial Regulators of Neuroinflammation and Astrocyte Modulation in Spinal Cord Injury. Cells 2024, 13, 581. [Google Scholar] [CrossRef] [PubMed]
- Bakleh, M.Z.; Al Haj Zen, A. The Distinct Role of HIF-1α and HIF-2α in Hypoxia and Angiogenesis. Cells 2025, 14, 673. [Google Scholar] [CrossRef] [PubMed]
- Canas-Marques, R.; Schnitt, S.J. E-Cadherin Immunohistochemistry in Breast Pathology: Uses and Pitfalls. Histopathology 2016, 68, 57–69. [Google Scholar] [CrossRef] [PubMed]
- Nouwen, E.J.; Dauwe, S.; Van Der Biest, I.; De Broe, M.E. Stage- and Segment-Specific Expression of Cell-Adhesion Molecules N-CAM, A-CAM, and L-CAM in the Kidney. Kidney Int. 1993, 44, 147–158. [Google Scholar] [CrossRef]
- Prozialeck, W.C.; Edwards, J.R. Cell Adhesion Molecules in Chemically-Induced Renal Injury. Pharmacol. Ther. 2007, 114, 74–93. [Google Scholar] [CrossRef]
- Lee, S.Y.; Han, S.M.; Kim, J.E.; Chung, K.Y.; Han, K.H. Expression of E-Cadherin in Pig Kidney. J. Vet. Sci. 2013, 14, 381. [Google Scholar] [CrossRef] [PubMed]
- Kienitz, R.; Kay, L.; Beuchat, I.; Gelhard, S.; von Brauchitsch, S.; Mann, C.; Lucaciu, A.; Schäfer, J.H.; Siebenbrodt, K.; Zöllner, J.P.; et al. Benzodiazepines in the Management of Seizures and Status Epilepticus: A Review of Routes of Delivery, Pharmacokinetics, Efficacy, and Tolerability. CNS Drugs 2022, 36, 951–975. [Google Scholar] [CrossRef] [PubMed]
- Wang, S.H.; Chen, W.S.; Tang, S.E.; Lin, H.C.; Peng, C.K.; Chu, H.T.; Kao, C.H. Benzodiazepines Associated with Acute Respiratory Failure in Patients with Obstructive Sleep Apnea. Front. Pharmacol. 2019, 9, 1513. [Google Scholar] [CrossRef] [PubMed]
- Lim, C.M.; Kim, M.S.; Ahn, J.J.; Kim, M.J.; Kwon, Y.; Lee, I.; Koh, Y.; Kim, D.S.; Kim, W.D. Hypothermia Protects against Endotoxin-Induced Acute Lung Injury in Rats. Intensive Care Med. 2003, 29, 453–459. [Google Scholar] [CrossRef]
- Gaines, P.; Chi, J.; Berliner, N. Heterogeneity of Functional Responses in Differentiated Myeloid Cell Lines Reveals EPRO Cells as a Valid Model of Murine Neutrophil Functional Activation. J. Leukoc. Biol. 2005, 77, 669–679. [Google Scholar] [CrossRef]
- Traphagen, N.; Tian, Z.; Allen-Gipson, D. Chronic Ethanol Exposure: Pathogenesis of Pulmonary Disease and Dysfunction. Biomolecules 2015, 5, 2840–2853. [Google Scholar] [CrossRef]
- Hoek, J.B.; Cahill, A.; Pastorino, J.G. Alcohol and Mitochondria: A Dysfunctional Relationship. Gastroenterology 2002, 122, 2049–2063. [Google Scholar] [CrossRef]
- Manzo-Avalos, S.; Saavedra-Molina, A. Cellular and Mitochondrial Effects of Alcohol Consumption. Int. J. Environ. Res. Public Health 2010, 7, 4281–4304. [Google Scholar] [CrossRef]
- Piano, M.R. Alcohol’s Effects on the Cardiovascular System. Alcohol Res. 2017, 38, 219. [Google Scholar]
- Leducq, N.; Bono, F.; Sulpice, T.; Vin, V.; Janiak, P.; Le Fur, G.; O’Connor, S.E.; Herbert, J.M. Role of Peripheral Benzodiazepine Receptors in Mitochondrial, Cellular, and Cardiac Damage Induced by Oxidative Stress and Ischemia-Reperfusion. J. Pharmacol. Exp. Ther. 2003, 306, 828–837. [Google Scholar] [CrossRef]
- Surinkaew, S.; Chattipakorn, S.; Chattipakorn, N. Roles of Mitochondrial Benzodiazepine Receptor in the Heart. Can. J. Cardiol. 2011, 27, 262.e3–262.e13. [Google Scholar] [CrossRef] [PubMed]
- Horioka, K.; Tanaka, H.; Okaba, K.; Yamada, S.; Ishii, N.; Motomura, A.; Inoue, H.; Alkass, K.; Druid, H.; Yajima, D. Hypothermia Causes Platelet Activation in the Human Spleen. Thromb. Res. 2021, 205, 47–55. [Google Scholar] [CrossRef] [PubMed]
- Grahovac, J.; Ivanković, M.; Dekić, R.; Paraš, S. Effects of Diazepam on Hematological and Histological Parameters in Rats/In Vivo and Unbiased Stereological Investigation. Acta Vet. 2022, 72, 235–255. [Google Scholar] [CrossRef]
- Shi, X.; DeLucia, A.L.; Bao, J.; Zhang, P. Alcohol Abuse and Disorder of Granulopoiesis. Pharmacol. Ther. 2019, 198, 206–219. [Google Scholar] [CrossRef]
- Medzhitov, R. Origin and Physiological Roles of Inflammation. Nature 2008, 454, 428–435. [Google Scholar] [CrossRef]
- Manz, M.G.; Boettcher, S. Emergency Granulopoiesis. Nat. Rev. Immunol. 2014, 14, 302–314. [Google Scholar] [CrossRef]
- Rock, K.L.; Latz, E.; Ontiveros, F.; Kono, H. The Sterile Inflammatory Response. Annu. Rev. Immunol. 2010, 28, 321–342. [Google Scholar] [CrossRef]
- Hyun, J.; Han, J.; Lee, C.; Yoon, M.; Jung, Y. Pathophysiological Aspects of Alcohol Metabolism in the Liver. Int. J. Mol. Sci. 2021, 22, 5717. [Google Scholar] [CrossRef]
- Chu, P.G.; Weiss, L.M. Keratin Expression in Human Tissues and Neoplasms. Histopathology 2002, 40, 403–439. [Google Scholar] [CrossRef]
- Gerostamoulos, D.; Schumann, J. Forensic Toxicology: Overview and Applications. In Encyclopedia of Forensic Sciences: Volume 1–4, 3rd ed.; Elsevier: Amsterdam, The Netherlands, 2022; Volume 2. [Google Scholar]
- Nunno, N.D.; Esposito, M.; Argo, A.; Salerno, M.; Sessa, F. Pharmacogenetics and Forensic Toxicology: A New Step towards a Multidisciplinary Approach. Toxics 2021, 11, 18. [Google Scholar] [CrossRef]
- European Council of Legal and Forensic Medicine Harmonization of Medico-Legal Autopsy. Available online: https://eclm.eu/en/documents/harmonization-of-medico-legal-autopsy-protocol/ (accessed on 21 January 2025).

| Organ | Group K (Control) | Group A (Alcohol) | Group B (Benzodiazepine) |
|---|---|---|---|
| Kidney | Hydropic and vacuolar degeneration, congestion; occasional acute tubular injury (eosinophilia, swelling, pyknotic nuclei); minimal lymphocytic infiltrate in interstitium. | Similar findings as Group K; occasional acute tubular injury and lymphocytic infiltrate. | Similar findings as Group K; occasional acute tubular injury and lymphocytic infiltrate. |
| Lungs | Congestion, emphysema, focal atelectasis, and intraalveolar and intraseptal hemorrhage, with emphysema most pronounced. | Slightly increased congestion, intraalveolar and intraseptal hemorrhage; emphysema less pronounced. | Similar to Group A with pronounced congestion, intraalveolar and intraseptal hemorrhage; less emphysema. |
| Heart | Congestion and erythrocyte extravasation in interstitium. | Similar to Group K, with some cardiomyocytes showing finely granular cytoplasm and vacuolar degeneration, suggesting protein denaturation. | Similar to Group K with occasional vacuolar degeneration and protein denaturation in cardiomyocytes. |
| Spleen | Preserved architecture with strong erythrocyte infiltration in red pulp. | Similar findings as Group K. | Similar findings as Group K. |
| Liver | Strong congestion with free erythrocytes in sinusoidal spaces; occasional hepatocyte necrosis with cytoplasmic granulation (potential protein denaturation). | Strong congestion, free erythrocytes in sinusoids; focal hepatocyte necrosis, subcapsular hemorrhage zones. | Strong congestion with similar necrosis and cytoplasmic granulation (suggesting protein denaturation). |
| Gastro-esophagus | Muscle layer hypertrophy, congestion, marked subepithelial eosinophilia. | Similar findings as Group K. | Similar findings as Group K. |
Disclaimer/Publisher’s Note: The statements, opinions and data contained in all publications are solely those of the individual author(s) and contributor(s) and not of MDPI and/or the editor(s). MDPI and/or the editor(s) disclaim responsibility for any injury to people or property resulting from any ideas, methods, instructions or products referred to in the content. |
© 2025 by the authors. Licensee MDPI, Basel, Switzerland. This article is an open access article distributed under the terms and conditions of the Creative Commons Attribution (CC BY) license (https://creativecommons.org/licenses/by/4.0/).
Share and Cite
Dervišević, E.; Čamdžić, N.; Lazović, E.; Salihbegović, A.; Sessa, F.; Spahović, H.; D’Errico, S. Histological and Immunohistochemical Evidence in Hypothermia-Related Death: An Experimental Study. Int. J. Mol. Sci. 2025, 26, 7578. https://doi.org/10.3390/ijms26157578
Dervišević E, Čamdžić N, Lazović E, Salihbegović A, Sessa F, Spahović H, D’Errico S. Histological and Immunohistochemical Evidence in Hypothermia-Related Death: An Experimental Study. International Journal of Molecular Sciences. 2025; 26(15):7578. https://doi.org/10.3390/ijms26157578
Chicago/Turabian StyleDervišević, Emina, Nina Čamdžić, Edina Lazović, Adis Salihbegović, Francesco Sessa, Hajrudin Spahović, and Stefano D’Errico. 2025. "Histological and Immunohistochemical Evidence in Hypothermia-Related Death: An Experimental Study" International Journal of Molecular Sciences 26, no. 15: 7578. https://doi.org/10.3390/ijms26157578
APA StyleDervišević, E., Čamdžić, N., Lazović, E., Salihbegović, A., Sessa, F., Spahović, H., & D’Errico, S. (2025). Histological and Immunohistochemical Evidence in Hypothermia-Related Death: An Experimental Study. International Journal of Molecular Sciences, 26(15), 7578. https://doi.org/10.3390/ijms26157578

